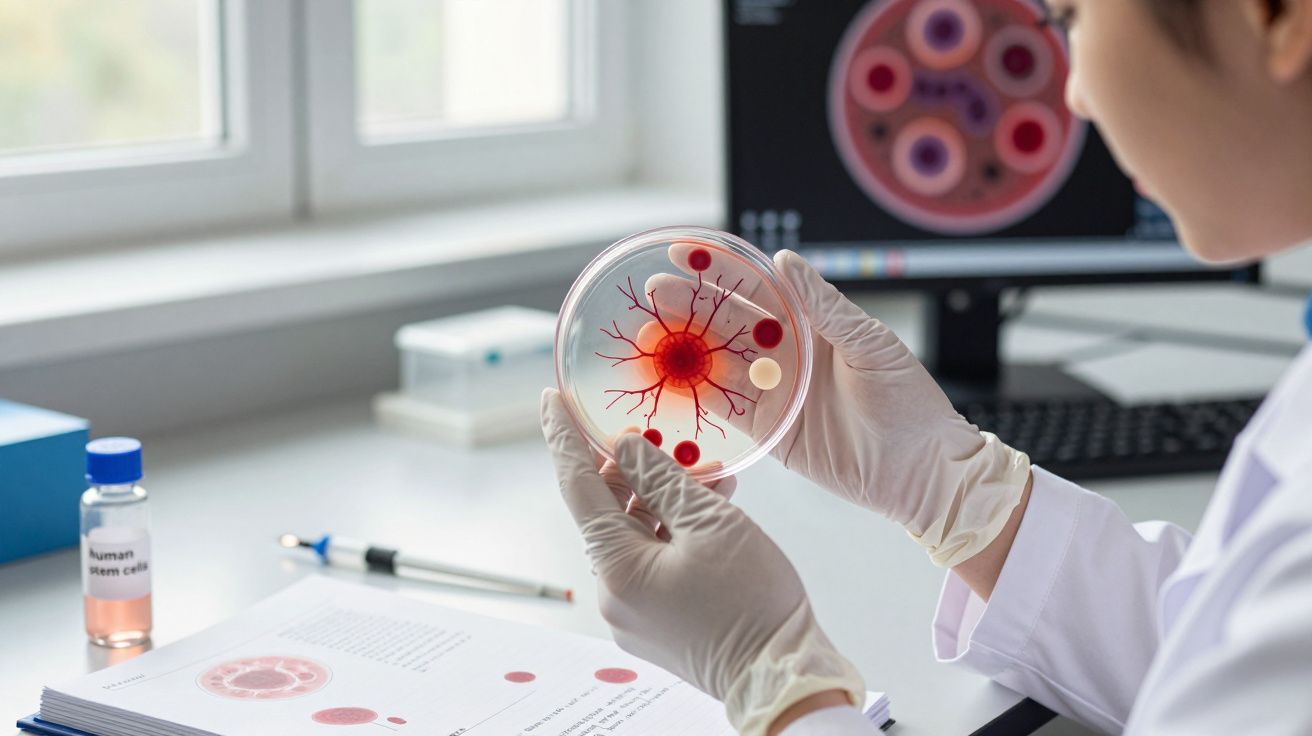
Investigador em laboratório a analisar cultura celular vermelha numa placa de Petri com luvas brancas.

Em poucas horas, um aviso saiu de páginas locais do Facebook, saltou para a televisão nacional e acabou em grupos de WhatsApp em modo pânico. De repente, houve quem passasse a imaginar bombas, gangues e desconhecidos a espreitar nas sombras do lugar de estacionamento.
Outros reagiram com desdém, como se fosse apenas mais uma vaga de pânico moral - a história perfeita para assustar numa semana noticiosa mais lenta. As capturas de ecrã continuaram a circular, e cada partilha trazia mais uma camada: medo, ironia ou sarcasmo. Entretanto, em garagens, caves e entradas de casas, a mesma pergunta ficou suspensa.
Será que ignorámos durante anos um risco mortal, ou estamos só a assistir a uma explosão de alarme mediático com luz azul por cima?
Medo por baixo do chassis: de onde vem, afinal, o aviso da Gendarmeria
Imagine a cena: manhã clara, rua calma num bairro residencial, chaves na mão. Vai um pouco atrasado, o café ainda está quente demais para beber. Desde o aviso da Gendarmeria, dá por si a lançar um olhar rápido para baixo do para-choques - meio a torcer para não ver nada, meio com receio de encontrar “qualquer coisa”.
Esse gesto, que antes parecia reservado a mecânicos e a personagens de filmes de acção, entrou de repente na rotina de pessoas comuns. Pais agacham-se à porta da escola, trabalhadores repetem o movimento em parques de estacionamento cheios, vizinhos comentam rumores junto à caixa do correio. Um texto curto, com aparência oficial, intrometeu-se num momento muito íntimo do dia-a-dia: aquele intervalo antes de ligar o motor, quando o dia ainda não começou “a sério”.
O aviso não surgiu do nada. Está ligado a investigações sobre criminosos que colocam localizadores GPS, embalagens de droga ou bens roubados na parte inferior dos veículos - muitas vezes junto às cavas das rodas ou atrás dos para-choques. Nalgumas zonas, as autoridades também referiram casos raros, mas muito chocantes, em que foram fixados dispositivos explosivos artesanais sob automóveis.
Esses episódios são excepcionais, mas marcam a imaginação. Tocam num medo primário: a ideia de que o perigo pode estar ali, silencioso, a poucos centímetros dos seus pés, escondido numa zona que quase ninguém verifica. A partir do momento em que essa possibilidade se instala, qualquer sombra sob um carro estacionado passa a parecer suspeita.
Os meios de comunicação agarraram rapidamente o tema porque tem todos os ingredientes de um título irresistível: investigações reais, uma ameaça fácil de visualizar e um gesto simples que supostamente “o protege”. O problema é o desfasamento entre um alerta policial pensado para contextos criminais específicos e a forma como ele é servido a milhões de condutores que só querem chegar ao trabalho.
É nesse desfasamento que nasce a tensão. De um lado, um apelo legítimo à vigilância. Do outro, uma torrente de notificações que transforma um detalhe de investigação numa ameaça permanente para qualquer pessoa com uma chave de carro. E nesse espaço, o medo corre sempre mais depressa do que os factos.
Como espreitar debaixo do carro sem entrar em paranóia
Há uma forma simples e prática de reagir, sem cair nem na paranoia total nem na negação absoluta. Pense nisto como uma “volta rápida de 10 segundos”, e não como um ritual de ansiedade. Aproxima-se do carro, dá uma volta completa à sua volta e, durante esse pequeno circuito, deixa o olhar varrer o chão e a parte inferior da carroçaria.
Não precisa de ferramentas, aparelhos nem treino “táctico”. Basta conhecer o normal do seu veículo: por onde passa o escape, onde terminam os plásticos, como costumam cair as sombras. Algo que pareça recentemente preso, pendurado, envolvido em fita adesiva, demasiado brilhante, magnetizado ou deslocado merece um segundo olhar. Na maioria dos dias não verá nada - e isso é, precisamente, a ideia.
Se estaciona muitas vezes em parques subterrâneos ou de grande rotação, acrescente um hábito mínimo: pare a cerca de 1 metro da porta do condutor e faça um meio-agachamento rápido, como se fosse apertar um atacador. Observe a linha do chassis de frente para trás. Depois de repetir algumas vezes, torna-se automático e quase imperceptível para quem está à volta.
Em ruas residenciais ou na sua própria entrada, um olhar mais calmo a cada poucos dias chega. Verifique a frente e a traseira, sobretudo se estaciona com o nariz encostado a uma parede. Não se trata de caçar ameaças a toda a hora: trata-se de ficar familiarizado com o “normal” por baixo do seu carro, para que qualquer novidade sobressaia - como um estranho numa fotografia de família.
A tentação, hoje, é ir às redes sociais e cair numa espiral de cenários catastróficos. É aí que o stress dispara. Mais útil é aceitar uma verdade simples: a esmagadora maioria dos condutores nunca vai encontrar nada perigoso debaixo do carro. O aviso da Gendarmeria vive na margem da probabilidade, não na rotina diária.
Sejamos francos: quase ninguém faz isto todos os dias como se estivesse numa série policial. O custo emocional da hiper-vigilância é real. Viver em estado de alerta permanente corrói a sensação de segurança mais do que a maioria dos riscos concretos alguma vez fará. O ponto de equilíbrio é adoptar hábitos de baixo esforço que se encaixem no que já faz.
E há um detalhe que muitas publicações oficiais não dizem com todas as letras: se vir algo estranho, não tem de bancar o herói. Não toque num dispositivo suspeito, numa embalagem ou num objecto com fios, por mais pequeno que pareça. Afaste-se, ligue para a polícia ou para a Gendarmeria, descreva o que está a ver, indique a localização e aguarde. Num dia normal, a chamada acaba com tranquilização e nada mais.
“Não estamos a pedir a cada condutor que seja especialista em explosivos”, explicou um agente da Gendarmeria, fora de câmara. “Estamos a pedir que reparem quando algo debaixo do próprio carro, de repente, não faz sentido estar ali.”
Para manter a cabeça fria, ajuda transformar conselhos soltos numa lista de verificação simples - e fácil de memorizar:
- Procure objectos novos fixos perto das rodas, do escape ou da zona do depósito de combustível.
- Confie no instinto se algo parecer recém-colado, preso com fita, magnetizado ou com aspeto “improvisado”.
- Afaste-se e contacte as autoridades em vez de tentar retirar coisas à mão.
- Use a luz do telemóvel se estiver num parque escuro e a visibilidade for fraca.
Um extra útil: sinais “normais” que evitam falsos alarmes
Há componentes que muitas pessoas não reconhecem e que podem parecer suspeitos à primeira vista: protecções plásticas, resguardos térmicos metálicos, suportes do escape, cabos e braçadeiras de fábrica, ou até lama e detritos agarrados após chuva. Se tiver dúvidas, compare com fotografias do mesmo modelo (ou peça a alguém numa oficina para confirmar numa revisão). A meta não é ver perigo em tudo - é conseguir distinguir o habitual do realmente novo.
Segurança no estacionamento: pequenas escolhas que reduzem oportunidades
Sem transformar isto numa obsessão, algumas decisões diminuem a probabilidade de adulteração: escolher zonas bem iluminadas, evitar lugares isolados, preferir parques com vigilância quando o carro vai ficar muitas horas e, sempre que possível, estacionar de forma a tornar difícil o acesso à traseira e às rodas (por exemplo, encostando-se mais a uma parede sem bloquear saídas). Se vive em condomínio, vale a pena reportar tentativas de intrusão na garagem à administração para reforçar iluminação ou controlo de acesso.
Entre risco real e ruído mediático: onde os condutores traçam a linha
Por trás do alerta viral há uma história maior: a forma como processamos o risco num mundo onde um crime local vira manchete nacional em minutos. Muitos condutores não acreditam, de facto, que haja bombas debaixo do carro à espera deles. O que sentem é um desconforto mais difuso: a sensação de que o perigo está em todo o lado e em lado nenhum - invisível, mas constantemente apontado por ecrãs e notificações.
Esse desconforto tem um preço. Pais somam esta “ameaça” a uma lista mental já pesada, que inclui acidentes rodoviários, adolescentes distraídos, condução sob efeito de álcool e estradas perigosas à noite. Uma publicação curta da Gendarmeria torna-se mais uma pedrinha numa mochila que já parece demasiado cheia. Ao mesmo tempo, ignorar por completo avisos oficiais soa imprudente - até egoísta - numa época em que todos são lembrados de que têm um papel na segurança colectiva.
Talvez por isso a ideia de verificar debaixo do carro divida tanto as pessoas. Para uns, é simples bom senso, como confirmar se um pneu não está totalmente vazio. Para outros, é mais uma instrução baseada no medo, parte de uma cultura que repete: “nunca estás verdadeiramente seguro”. A realidade tende a ficar num meio-termo desconfortável, onde perigos reais (mas raros) convivem com manchetes que fogem ao contexto.
Nesse terreno intermédio, pequenas acções exequíveis fazem sentido - desde que não tomem conta da sua vida. Um olhar rápido por baixo do para-choques não precisa de carregar a ansiedade do mundo. É só um hábito discreto e prático, como fechar a porta de casa à chave ou testar um detector de fumo de vez em quando. No resto do tempo, o carro volta a ser apenas um carro - e não um adereço de suspense de um noticiário nocturno.
| Ponto-chave | Detalhes | Porque é importante para quem lê |
|---|---|---|
| O que a Gendarmeria realmente alertou | Investigações recentes identificaram casos de localizadores GPS, embrulhos de droga e bens roubados colocados sob veículos e, em situações raras, dispositivos improvisados; por isso, os agentes recomendaram verificações visuais ocasionais antes de conduzir. | Compreender o contexto real ajuda a separar conselhos legítimos de segurança de pânico online e a escolher um nível de vigilância sensato para a sua rotina. |
| Como fazer uma verificação de 10 segundos | Dê uma volta ao veículo, espreite rapidamente a frente e a traseira e observe a zona perto das rodas e do escape, procurando objectos novos, itens colados com fita ou caixas incomuns que não estavam lá antes. | Encaixa numa manhã normal sem se tornar obsessão e aumenta a probabilidade de detectar adulterações ou danos cedo. |
| Quando um objecto estranho é mesmo suspeito | Elementos que pareçam recém-fixados, magnetizados ou com fios, sobretudo perto do depósito de combustível ou das cavas das rodas, justificam afastamento, uma foto à distância e contacto com a polícia ou a Gendarmeria - não remoção “caseira”. | Saber distinguir detritos inofensivos de um sinal de alerta permite agir com calma, evitar pânico desnecessário e manter-se fisicamente seguro se houver risco real. |
Perguntas frequentes
Os condutores correm um risco elevado de encontrar uma bomba debaixo do carro?
Os casos conhecidos são extremamente raros e, regra geral, associados a contextos criminais específicos ou conflitos pessoais - não a ataques aleatórios a automobilistas comuns. Por isso se fala em vigilância pontual, e não em perigo permanente.Com que frequência faz sentido espreitar debaixo do veículo?
Para a maioria das pessoas, uma verificação visual rápida a cada poucos dias, ou sempre que o carro esteve muito tempo estacionado num local público ou desconhecido, é um equilíbrio realista entre segurança e tranquilidade.E se eu não tiver capacidade física para me agachar ou dobrar?
Pode usar a câmara e a lanterna do telemóvel estendendo o braço pela lateral do carro, ou pedir a um familiar, vizinho ou oficina para confirmar quando estiverem por perto, sem forçar movimentos desconfortáveis.O próprio aviso pode gerar mais stress do que segurança?
Sim, sobretudo se for comunicado como ameaça constante e universal. Transformar a mensagem num hábito simples e de baixo esforço mantém o tema no lugar certo e evita que a ansiedade domine sempre que pega nas chaves.Vale a pena comprar espelhos ou ferramentas especiais para inspeccionar a parte inferior do carro?
Para o condutor médio, é excessivo. Um olhar básico à volta da zona inferior, com luz razoável, já oferece um nível útil de atenção sem equipamento adicional.

Comentários
Ainda não há comentários. Seja o primeiro!
Deixar um comentário